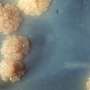

‘Avatar: Fire & Ash’ Success Lifts Imax Quarterly Earnings
James Cameron’s return to Pandora with “Avatar: Fire & Ash” meant big business for Imax. Revenue at the exhibition technology company climbed 35% to $125.2 million for the fourth quarter of 2025, compared to $92.7 million in the year-ago period. The company said that the third